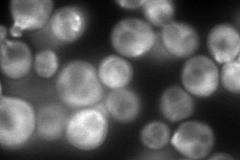
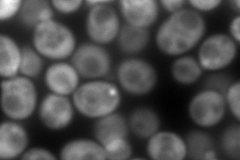
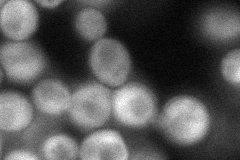

View description
Major isoform of tropomyosin; binds to and stabilizes actin cables and filaments, which direct polarized cell growth and the distribution of several organelles; acetylated by the NatB complex and acetylated form binds actin most efficiently
Localization:
Intensity:
Fold change:
Significance:
-
C’ GFP library in SD

below threshold15.02 -
N' NOP1pr-GFP in SD
cytosol,bud340.122 -
N' TEF2pr-mCherry in SD
cytosol589.639 -
N' NATIVEpr-GFP in SD

punctate,bud173.667 -
N' TEF2pr-VC and Cyto-VN in SD
cytosol78.8178 -
C’ GFP library in SD+DTT

cytosolN/AN/ANo -
C’ GFP library in SD+H2O2

cytosolN/AN/ANo -
C’ GFP library in Starvation Media

cytosolN/AN/AYes -
C’ GFP library on the background of Pup2-DaMP

below threshold -
C’ GFP library on the background of CCT mutant

below thresholdN/AN/ANo
